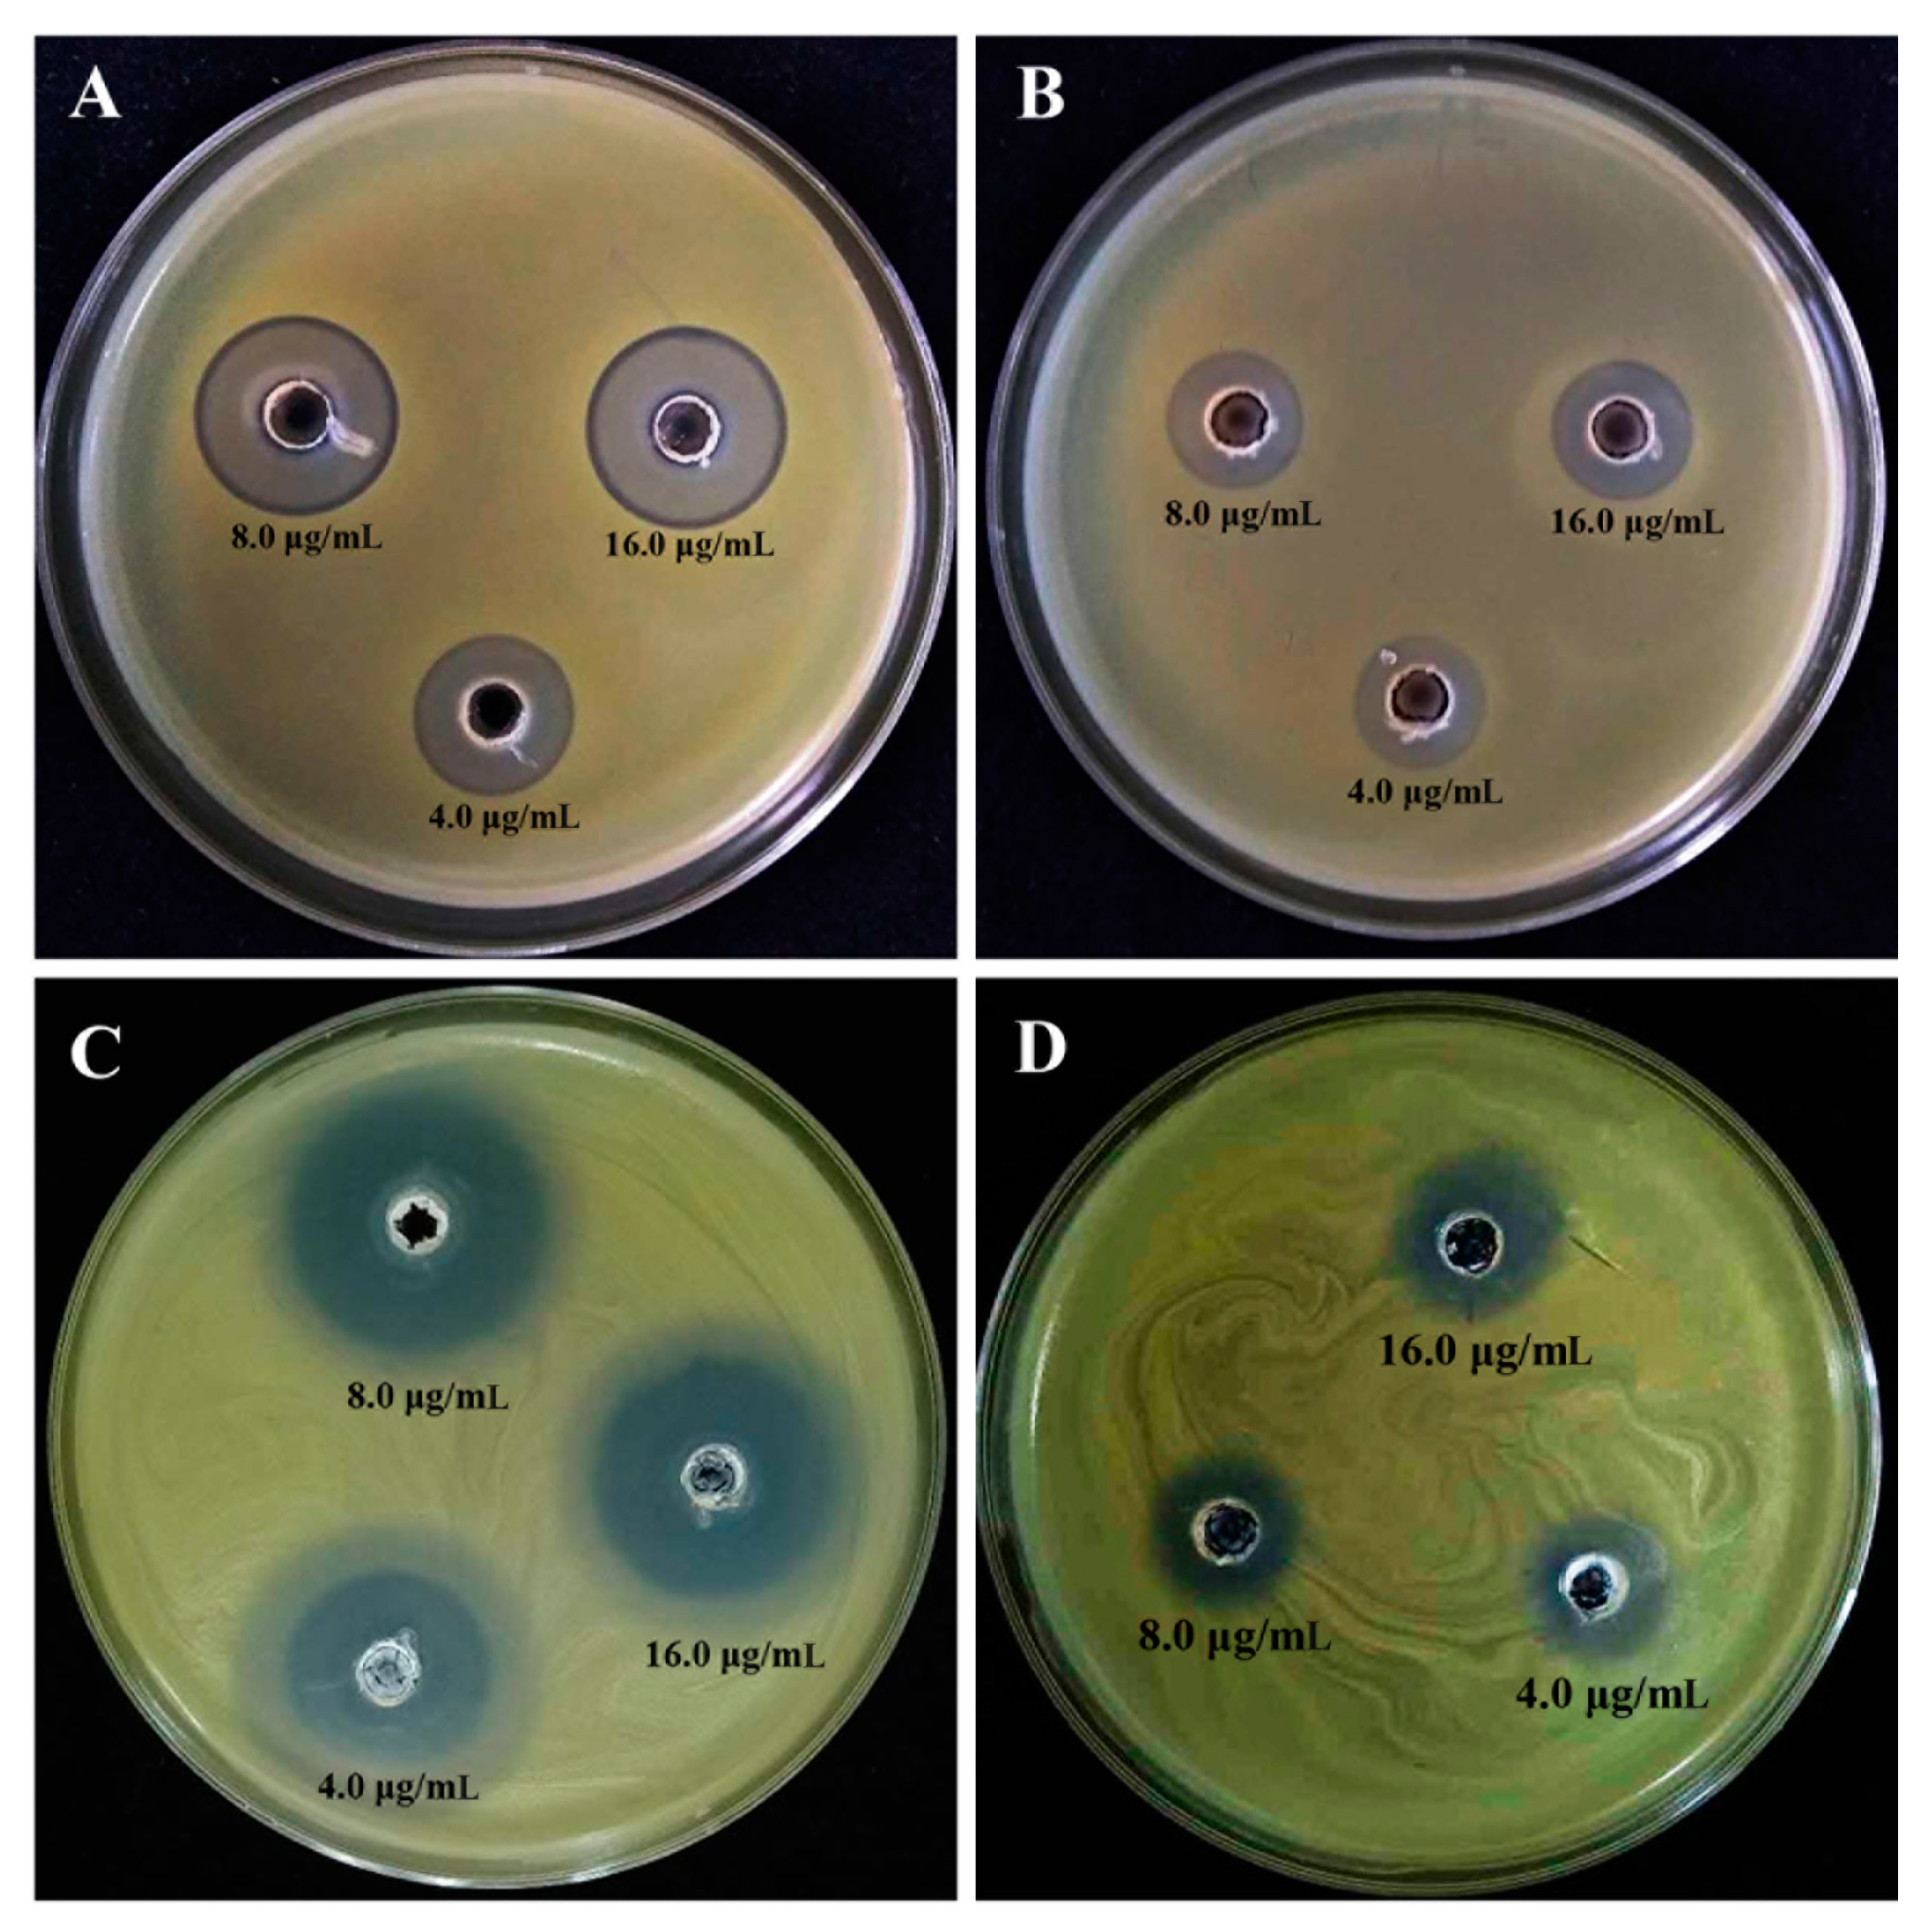
Molecules 25 04795 g005 Molecules 25 04795 g005

Bioinspired Green Synthesis of Chitosan and Zinc Oxide Nanoparticles with Strong Antibacterial Activity against Rice Pathogen Xanthomonas oryzae pv. oryzae
Abstract
1. Introduction
2. Materials and Methods
2.1. Preparation of Aqueous Green Tomato Extract
2.2. Green Synthesis of CSNPs and ZnONPs
2.3. Characterization of CSNPs and ZnONPs with Strong Antibacterial Activities
2.3.1. Analysis of UV-Vis Spectroscopy
2.3.2. TEM and SEM-EDS Observation
2.3.3. FTIR Analysis
2.3.4. XRD Analysis
2.4. Antibacterial Activity and Mechanism of Action
2.4.1. Measurement of Bacterial Growth
2.4.2. Assay of Biofilm Formation
2.4.3. Assay of Bacterial Motility
2.4.4. TEM Observation of Bacterial Cells
2.4.5. Flow Cytometric Analysis of Bacterial Cells
2.4.6. Determination of Bacterial Reactive Oxygen Species (ROS)
2.5. Statistical Analysis
3. Results and Discussion
3.1. Biosynthesis of CSNPs and ZnONPs
3.2. Characterization of CSNPs and ZnONPs
3.2.1. TEM and SEM-EDS Observation
3.2.2. FTIR Analysis
3.2.3. XRD Analysis
3.3. Antibacterial Activity of CSNPs and ZnONPs
3.3.1. In Vitro Inhibitory Effect on the Growth of Xoo
3.3.2. Inhibition of Biofilm Formation and Motility Swimming
3.3.3. TEM Observation of Cell Damage
3.3.4. FC Observation of the Apoptosis of Xoo Cells
3.3.5. CLSM Observation of ROS Generation
4. Conclusions
Author Contributions
Funding
Conflicts of Interest
References
- Bora, P.S.L.; Baruah, K.P.A.; Talukdar, R.B.K.; Kataky, L.; Phukan, A. Review on Bacterial Blight of rice caused by Xanthomonas oryzae pv. oryzae: Different management approaches and role of Pseudomonas fluorescens as a potential biocontrol agent. Int. J. Curr. Microbiol. Appl. Sci. 2017, 6, 982–1005. [Google Scholar] [CrossRef]
- Ahmed, S.; Annu; Chaudhry, S.A.; Ikram, S. A review on biogenic synthesis of ZnO nanoparticles using plant extracts and microbes: A prospect towards green chemistry. J. Photochem. Photobiol. B Biol. 2017, 166, 272–284. [Google Scholar] [CrossRef]
- Singh, A.; Singh, N.; Hussain, I.; Singh, H.; Yadav, V.; Singh, S. Green synthesis of nano zinc oxide and evaluation of its impact on germination and metabolic activity of Solanum lycopersicum. J. Biotechnol. 2016, 233, 84–94. [Google Scholar] [CrossRef]
- Baek, S.; Joo, S.H.; Blackwelder, P.; Toborek, M. Effects of coating materials on antibacterial properties of industrial and sunscreen-derived titanium-dioxide nanoparticles on Escherichia coli. Chemosphere 2018, 208, 196–206. [Google Scholar] [CrossRef]
- Pomastowski, P.; Król-Górniak, A.; Railean-Plugaru, V.; Buszewski, B. Zinc Oxide Nanocomposites—Extracellular Synthesis, Physicochemical Characterization and Antibacterial Potential. Materials 2020, 13, 4347. [Google Scholar] [CrossRef]
- Mittal, A.K.; Chisti, Y.; Banerjee, U.C. Synthesis of metallic nanoparticles using plant extracts. Biotechnol. Adv. 2013, 31, 346–356. [Google Scholar] [CrossRef]
- Basnet, P.; Chanu, T.I.; Samanta, D.; Chatterjee, S. A review on bio-synthesized zinc oxide nanoparticles using plant extracts as reductants and stabilizing agents. J. Photochem. Photobiol. B Biol. 2018, 183, 201–221. [Google Scholar] [CrossRef] [PubMed]
- Elwan, H.A.M.; ElNesr, S.S.; Mohany, M.; Al-Rejaie, S.S. The effects of dietary tomato powder (Solanum lycopersicum L.) supplementation on the haematological, immunological, serum biochemical and antioxidant parameters of growing rabbits. J. Anim. Physiol. Anim. Nutr. 2018, 103, 534–546. [Google Scholar] [CrossRef] [PubMed]
- Friedman, M. Tomato Glycoalkaloids: Role in the Plant and in the Diet. J. Agric. Food Chem. 2002, 50, 5751–5780. [Google Scholar] [CrossRef] [PubMed]
- Rodriguez, J.; Rios, D.; Rodriguez, E.; Diaz, C. Physico-Chemical Changes During Ripening of Conventionally, Ecologically and Hydroponically Cultivated Tyrlain (TY 10016) Tomatoes. Int. J. Agric. Res. 2006, 1, 452–461. [Google Scholar] [CrossRef]
- Nagaonkar, D.; Gaikwad, S.; Rai, M. Catharanthus roseus leaf extract-synthesized chitosan nanoparticles for controlled in vitro release of chloramphenicol and ketoconazole. Colloid Polym. Sci. 2015, 293, 1465–1473. [Google Scholar] [CrossRef]
- Sutradhar, P.; Saha, M. Green synthesis of zinc oxide nanoparticles using tomato (Lycopersicon esculentum) extract and its photovoltaic application. J. Exp. Nanosci. 2015, 11, 314–327. [Google Scholar] [CrossRef]
- Wang, L.; Hu, C.; Shao, L. The antimicrobial activity of nanoparticles: Present situation and prospects for the future. Int. J. Nanomed. 2017, 12, 1227–1249. [Google Scholar] [CrossRef] [PubMed]
- Predoi, D.; Iconaru, S.L.; Predoi, D. Fabrication of Silver- and Zinc-Doped Hydroxyapatite Coatings for Enhancing Antimicrobial Effect. Coatings 2020, 10, 905. [Google Scholar] [CrossRef]
- Li, B.; Wang, X.; Chen, R.; Huangfu, W.; Xie, G. Antibacterial activity of chitosan solution against Xanthomonas pathogenic bacteria isolated from Euphorbia pulcherrima. Carbohydr. Polym. 2008, 72, 287–292. [Google Scholar] [CrossRef]
- Abdallah, Y.; Ogunyemi, S.O.; Abdelazez, A.; Zhang, M.; Hong, X.; Ibrahim, E.; Hossain, A.; Fouad, H.; Li, B.; Chen, J. The Green Synthesis of MgO Nano-Flowers Using Rosmarinus officinalis L. (Rosemary) and the Antibacterial Activities against Xanthomonas oryzae pv. oryzae. Bio Med. Res. Int. 2019, 2019, 1–8. [Google Scholar] [CrossRef] [PubMed]
- Ibrahim, E.; Fouad, H.; Zhang, M.; Zhang, Y.; Qiu, W.; Yan, C.; Li, B.; Mo, J.; Chen, J. Biosynthesis of silver nanoparticles using endophytic bacteria and their role in inhibition of rice pathogenic bacteria and plant growth promotion. RSC Adv. 2019, 9, 29293–29299. [Google Scholar] [CrossRef]
- Ahmed, T.; Shahid, M.; Noman, M.; Niazi, M.B.K.; Mahmood, F.; Manzoor, I.; Zhang, Y.; Li, B.; Yang, Y.; Yan, C.; et al. Silver Nanoparticles Synthesized by Using Bacillus cereus SZT1 Ameliorated the Damage of Bacterial Leaf Blight Pathogen in Rice. Pathogens 2020, 9, 160. [Google Scholar] [CrossRef]
- Ogunyemi, S.O.; Abdallah, Y.; Zhang, M.; Fouad, H.; Hong, X.; Ibrahim, E.; Masum, M.I.; Hossain, A.; Mo, J.; Li, B. Green synthesis of zinc oxide nanoparticles using different plant extracts and their antibacterial activity against Xanthomonas oryzae pv. oryzae. Artif. Cells Nanomed. Biotechnol. 2019, 47, 341–352. [Google Scholar] [CrossRef]
- Maruyama, C.R.; Guilger, M.; Pascoli, M.; Bileshy-José, N.; Abhilash, P.; Fraceto, L.F.; De Lima, R. Nanoparticles Based on Chitosan as Carriers for the Combined Herbicides Imazapic and Imazapyr. Sci. Rep. 2016, 6, 19768. [Google Scholar] [CrossRef]
- Campos, E.V.R.; Proença, P.L.F.; Oliveira, J.L.; Melville, C.C.; Della Vechia, J.F.; De Andrade, D.J.; Fraceto, L.F. Chitosan nanoparticles functionalized with β-cyclodextrin: A promising carrier for botanical pesticides. Sci. Rep. 2018, 8, 2067. [Google Scholar] [CrossRef] [PubMed]
- Wang, W.; Hao, X.; Chen, S.; Yang, Z.; Wang, C.; Yan, R.; Zhang, X.; Liu, H.; Shao, Q.; Guo, Z. pH-responsive Capsaicin@chitosan nanocapsules for antibiofouling in marine applications. Polymer 2018, 158, 223–230. [Google Scholar] [CrossRef]
- Li, B.; Zhang, Y.; Yang, Y.; Qiu, W.; Wang, X.; Liu, B.; Wang, Y.; Sun, G.-C. Synthesis, characterization, and antibacterial activity of chitosan/TiO2 nanocomposite against Xanthomonas oryzae pv. oryzae. Carbohydr. Polym. 2016, 152, 825–831. [Google Scholar] [CrossRef] [PubMed]
- Agnihotri, S.A.; Mallikarjuna, N.N.; Aminabhavi, T. Recent advances on chitosan-based micro- and nanoparticles in drug delivery. J. Control. Release 2004, 100, 5–28. [Google Scholar] [CrossRef]
- Zhang, C.; Qu, G.; Sun, Y.; Yang, T.; Yao, Z.; Shen, W.; Shen, Z.; Ding, Q.; Zhou, H.; Ping, Q. Biological evaluation of N-octyl-O-sulfate chitosan as a new nano-carrier of intravenous drugs. Eur. J. Pharm. Sci. 2008, 33, 415–423. [Google Scholar] [CrossRef]
- Dube, A.; Nicolazzo, J.A.; Larson, I. Chitosan nanoparticles enhance the intestinal absorption of the green tea catechins (+)-catechin and (−)-epigallocatechin gallate. Eur. J. Pharm. Sci. 2010, 41, 219–225. [Google Scholar] [CrossRef]
- Ghadi, A.; Mahjoub, S.; Tabandeh, F.; Talebnia, F. Synthesis and optimization of chitosan nanoparticles: Potential applications in nanomedicine and biomedical engineering. Casp. J. Intern. Med. 2014, 5, 156–161. [Google Scholar]
- Yahya, E.B.; Jummaat, F.; Amirul, A.A.; Adnan, A.; Olaiya, N.; Abdullah, C.; Rizal, S.; Haafiz, M.M.; Khalil, H.A. A Review on Revolutionary Natural Biopolymer-Based Aerogels for Antibacterial Delivery. Antibiotics 2020, 9, 648. [Google Scholar] [CrossRef]
- Sullivan, D.J.; Cruz-Romero, M.; Collins, T.; Cummins, E.; Kerry, J.P.; Morris, M.A. Synthesis of monodisperse chitosan nanoparticles. Food Hydrocoll. 2018, 83, 355–364. [Google Scholar] [CrossRef]
- Zeng, Z.W.; Wang, J.J.; Xiao, R.Z.; Xie, T.; Zhou, G.L.; Zhan, X.R.; Wang, S.L. Recent advances of chitosan nanoparticles as drug carriers. Int. J. Nanomed. 2011, 6, 765–774. [Google Scholar] [CrossRef]
- Anand, M.; Sathyapriya, P.; Maruthupandy, M.; Beevi, A.H. Synthesis of chitosan nanoparticles by TPP and their potential mosquito larvicidal application. Front. Lab. Med. 2018, 2, 72–78. [Google Scholar] [CrossRef]
- Liu, T.; Wang, J.; Chi, F.; Tan, Z.; Liu, L. Development and Characterization of Novel Active Chitosan Films Containing Fennel and Peppermint Essential Oils. Coatings 2020, 10, 936. [Google Scholar] [CrossRef]
- Ahmed, T.; Noman, M.; Shahid, M.; Niazi, M.B.K.; Hussain, S.; Manzoor, N.; Wang, X.; Li, B. Green synthesis of silver nanoparticles transformed synthetic textile dye into less toxic intermediate molecules through LC-MS analysis and treated the actual wastewater. Environ. Res. 2020, 110142. [Google Scholar] [CrossRef] [PubMed]
- Ahmed, T.; Shahid, M.; Noman, M.; Niazi, M.B.K.; Zubair, M.; Almatroudi, A.; Khurshid, M.; Tariq, F.; Mumtaz, R.; Li, B. Bioprospecting a native silver-resistant Bacillus safensis strain for green synthesis and subsequent antibacterial and anticancer activities of silver nanoparticles. J. Adv. Res. 2020, 24, 475–483. [Google Scholar] [CrossRef]
- Hossain, A.; Abdallah, Y.; Ali, M.A.; Masum, M.M.I.; Li, B.; Sun, G.; Meng, Y.; Wang, Y.; An, Q. Lemon-Fruit-Based Green Synthesis of Zinc Oxide Nanoparticles and Titanium Dioxide Nanoparticles against Soft Rot Bacterial Pathogen Dickeya dadantii. Biomolecules 2019, 9, 863. [Google Scholar] [CrossRef]
- Perez, C. Antibiotic assay by agar-well diffusion method. Acta Biol. Med. Exp. 1990, 15, 113–115. [Google Scholar]
- Wiegand, I.; Hilpert, K.; Hancock, R.E.W. Agar and broth dilution methods to determine the minimal inhibitory concentration (MIC) of antimicrobial substances. Nat. Protoc. 2008, 3, 163–175. [Google Scholar] [CrossRef]
- Zhang, L.; Xu, J.; Xu, J.; Zhang, H.; He, L.; Feng, J. TssB is essential for virulence and required for Type VI secretion system in Ralstonia solanacearum. Microb. Pathog. 2014, 74, 1–7. [Google Scholar] [CrossRef]
- Raza, W.; Ling, N.; Yang, L.; Huang, Q.; Shen, Q. Response of tomato wilt pathogen Ralstonia solanacearum to the volatile organic compounds produced by a biocontrol strain Bacillus amyloliquefaciens SQR-9. Sci. Rep. 2016, 6, 24856. [Google Scholar] [CrossRef]
- Sun, D.; Zhang, W.; Mou, Z.; Chen, Y.; Guo, F.; Yang, E.; Wang, W. Transcriptome Analysis Reveals Silver Nanoparticle-Decorated Quercetin Antibacterial Molecular Mechanism. ACS Appl. Mater. Interfaces 2017, 9, 10047–10060. [Google Scholar] [CrossRef]
- Cai, L.; Chen, J.; Liu, Z.; Wang, H.; Yang, H.; Ding, W. Magnesium Oxide Nanoparticles: Effective Agricultural Antibacterial Agent Against Ralstonia solanacearum. Front. Microbiol. 2018, 9, 790. [Google Scholar] [CrossRef]
- Applerot, G.; Lellouche, J.; Lipovsky, A.; Nitzan, Y.; Lubart, R.; Gedanken, A.; Banin, E. Understanding the Antibacterial Mechanism of CuO Nanoparticles: Revealing the Route of Induced Oxidative Stress. Small 2012, 8, 3326–3337. [Google Scholar] [CrossRef] [PubMed]
- Oh, J.-W.; Chun, S.; Chandrasekaran, M. Preparation and In Vitro Characterization of Chitosan Nanoparticles and Their Broad-Spectrum Antifungal Action Compared to Antibacterial Activities against Phytopathogens of Tomato. Agronomy 2019, 9, 21. [Google Scholar] [CrossRef]
- Ahamed, M.; Akhtar, M.J.; Kumar, S.; Khan, M.M.; Ahmad, J.; A Alrokayan, S. Zinc oxide nanoparticles selectively induce apoptosis in human cancer cells through reactive oxygen species. Int. J. Nanomed. 2012, 7, 845–857. [Google Scholar] [CrossRef] [PubMed]
- Wanichwecharungruang, S.P. Chitosan-Nanoparticle as UV Filter and Carrier for Cosmetic Actives. In Technical Proceedings of the 2007 NSTI Nanotechnology Conference and Trade Show, Santa Clara, CA, USA, 20–24 May 2007; pp. 257–260. [Google Scholar]
- Sharma, D.; Rajput, J.; Kaith, B.; Kaur, M.; Sharma, S. Synthesis of ZnO nanoparticles and study of their antibacterial and antifungal properties. Thin Solid Films 2010, 519, 1224–1229. [Google Scholar] [CrossRef]
- Parida, U.K.; Rout, N.; Bindhani, B.K. In vitro properties of chitosan nanoparticles induce apoptosis in human lymphoma SUDHL-4 cell line. Adv. Biosci. Biotechnol. 2013, 4, 1118–1127. [Google Scholar] [CrossRef]
- Ilk, S.; Saglam, N.; Özgen, M. Kaempferol loaded lecithin/chitosan nanoparticles: Preparation, characterization, and their potential applications as a sustainable antifungal agent. Artif. Cells Nanomed. Biotechnol. 2016, 45, 907–916. [Google Scholar] [CrossRef]
- Fu, L.; Fu, Z. Plectranthus amboinicus leaf extract–assisted biosynthesis of ZnO nanoparticles and their photocatalytic activity. Ceram. Int. 2015, 41, 2492–2496. [Google Scholar] [CrossRef]
- Sotelo-Boyás, M.; Valverde-Aguilar, G.; Plascencia-Jatomea, M.; Correa-Pacheco, Z.; Jiménez-Aparicio, A.; Solorza-Feria, J.; Barrera-Necha, L.; Bautista-Banos, S. Characterization of chitosan nanoparticles added with essential oils. in vitro effect on Pectobacterium carotovorum. Rev. Mex. Ing. Quim. 2015, 14, 589–599. [Google Scholar]
- Ali, J.; Irshad, R.; Li, B.; Tahir, K.; Ahmad, A.; Shakeel, M.; Khan, N.U.; Khan, Z.U.H. Synthesis and characterization of phytochemical fabricated zinc oxide nanoparticles with enhanced antibacterial and catalytic applications. J. Photochem. Photobiol. B Biol. 2018, 183, 349–356. [Google Scholar] [CrossRef]
- Senthilkumar, S.; Sivakumar, T. Green tea (Camellia sinensis) mediated synthesis of zinc oxide (ZnO) nanoparticles and studies on their antimicrobial activities. Int. J. Pharm. Pharm. Sci. 2014, 6, 461–465. [Google Scholar]
- Salehizadeh, H.; Hekmatian, E.; Sadeghi, M.; Kennedy, K.J. Synthesis and characterization of core-shell Fe3O4-gold-chitosan nanostructure. J. Nanobiotechnol. 2012, 10, 3. [Google Scholar] [CrossRef] [PubMed]
- Hedayati, K. Fabrication and optical characterization of zinc oxide nanoparticles prepared via a simple sol-gel method. J. Nanostruct. 2015, 5, 395–401. [Google Scholar] [CrossRef]
- Yedurkar, S.; Maurya, C.; Mahanwar, P. Biosynthesis of Zinc Oxide Nanoparticles Using Ixora Coccinea Leaf Extract—A Green Approach. Open J. Synth. Theory Appl. 2016, 5, 1–14. [Google Scholar] [CrossRef]
- Yen, M.-T.; Yang, J.-H.; Mau, J.-L. Physicochemical characterization of chitin and chitosan from crab shells. Carbohydr. Polym. 2009, 75, 15–21. [Google Scholar] [CrossRef]
- El Zowalaty, M.E.; Ibrahim, N.A.; Salama, M.; Shameli, K.; Usman, M.S.; Zainuddin, N. Synthesis, characterization, and antimicrobial properties of copper nanoparticles. Int. J. Nanomed. 2013, 8, 4467–4479. [Google Scholar] [CrossRef]
- Gupta, A.; Srivastava, P.; Bahadur, L.; Amalnerkar, D.P.; Chauhan, R. Comparison of physical and electrochemical properties of ZnO prepared via different surfactant-assisted precipitation routes. Appl. Nanosci. 2014, 5, 787–794. [Google Scholar] [CrossRef]
- Mahendra, C.; Murali, M.; Manasa, G.; Ponnamma, P.; Abhilash, M.; Lakshmeesha, T.; Satish, A.; Amruthesh, K.; Sudarshana, M. Antibacterial and antimitotic potential of bio-fabricated zinc oxide nanoparticles of Cochlospermum religiosum (L.). Microb. Pathog. 2017, 110, 620–629. [Google Scholar] [CrossRef]
- Mishra, S.; Yang, X.; Ray, S.; Fraceto, L.F.; Singh, H. Antibacterial and biofilm inhibition activity of biofabricated silver nanoparticles against Xanthomonas oryzae pv. oryzae causing blight disease of rice instigates disease suppression. World J. Microbiol. Biotechnol. 2020, 36, 1–10. [Google Scholar] [CrossRef]
- Majumdar, T.D.; Singh, M.; Thapa, M.; Dutta, M.; Mukherjee, A.; Ghosh, C.K. Size-dependent antibacterial activity of copper nanoparticles against Xanthomonas oryzae pv. oryzae—A synthetic and mechanistic approach. Colloid Interface Sci. Commun. 2019, 32, 100190. [Google Scholar] [CrossRef]
- Bridier, A.; Briandet, R.; Thomas, V.; Dubois-Brissonnet, F. Resistance of bacterial biofilms to disinfectants: A review. Biofouling 2011, 27, 1017–1032. [Google Scholar] [CrossRef]
- De Paz, L.E.C.; Resin, A.; Howard, K.A.; Sutherland, D.S.; Wejse, P.L. Antimicrobial Effect of Chitosan Nanoparticles on Streptococcus mutans Biofilms. Appl. Environ. Microbiol. 2011, 77, 3892–3895. [Google Scholar] [CrossRef] [PubMed]
- Tamara, F.R.; Lin, C.; Mi, F.-L.; Ho, Y.-C. Antibacterial Effects of Chitosan/Cationic Peptide Nanoparticles. Nanomater. 2018, 8, 88. [Google Scholar] [CrossRef] [PubMed]
- Lee, J.-H.; Kim, Y.-G.; Cho, M.H.; Lee, J. ZnO nanoparticles inhibit Pseudomonas aeruginosa biofilm formation and virulence factor production. Microbiol. Res. 2014, 169, 888–896. [Google Scholar] [CrossRef] [PubMed]
- Tiwari, V.; Mishra, N.; Gadani, K.; Solanki, P.S.; Shah, N.A.; Tiwari, M. Mechanism of Anti-bacterial Activity of Zinc Oxide Nanoparticle Against Carbapenem-Resistant Acinetobacter baumannii. Front. Microbiol. 2018, 9, 1218. [Google Scholar] [CrossRef] [PubMed]
- Wang, Q.; Zuo, J.; Wang, Q.; Na, Y.; Gao, L.-P. Inhibitory effect of chitosan on growth of the fungal phytopathogen, Sclerotinia sclerotiorum, and sclerotinia rot of carrot. J. Integr. Agric. 2015, 14, 691–697. [Google Scholar] [CrossRef]
- Xie, Y.; He, Y.; Irwin, P.L.; Jin, T.; Shi, X. Antibacterial Activity and Mechanism of Action of Zinc Oxide Nanoparticles against Campylobacter jejuni. Appl. Environ. Microbiol. 2011, 77, 2325–2331. [Google Scholar] [CrossRef]
- Ai, H.; Wang, F.; Xia, Y.; Chen, X.; Lei, C. Antioxidant, antifungal and antiviral activities of chitosan from the larvae of housefly, Musca domestica L. Food Chem. 2012, 132, 493–498. [Google Scholar] [CrossRef]
- Chang, S.-H.; Lin, H.-T.V.; Wu, G.-J.; Tsai, G.J. pH Effects on solubility, zeta potential, and correlation between antibacterial activity and molecular weight of chitosan. Carbohydr. Polym. 2015, 134, 74–81. [Google Scholar] [CrossRef]
- Pilon, L.; Spricigo, P.C.; Miranda, M.; De Moura, M.R.; Assis, O.B.G.; Mattoso, L.H.; Ferreira, M.D. Chitosan nanoparticle coatings reduce microbial growth on fresh-cut apples while not affecting quality attributes. Int. J. Food Sci. Technol. 2014, 50, 440–448. [Google Scholar] [CrossRef]
- Jin, T.; Sun, D.; Su, J.; Zhang, H.; Sue, H.-J. Antimicrobial Efficacy of Zinc Oxide Quantum Dots againstListeria monocytogenes, Salmonella Enteritidis, and Escherichia coli O157:H7. J. Food Sci. 2009, 74, M46–M52. [Google Scholar] [CrossRef] [PubMed]
- Kumar, A.; Pandey, A.K.; Singh, S.S.; Shanker, R.; Dhawan, A. Engineered ZnO and TiO2 nanoparticles induce oxidative stress and DNA damage leading to reduced viability of Escherichia coli. Free Radic. Biol. Med. 2011, 51, 1872–1881. [Google Scholar] [CrossRef] [PubMed]
- Banerjee, M.; Mallick, S.; Paul, A.; Chattopadhyay, A.; Ghosh, S.S. Heightened Reactive Oxygen Species Generation in the Antimicrobial Activity of a Three Component Iodinated Chitosan−Silver Nanoparticle Composite. Langmuir 2010, 26, 5901–5908. [Google Scholar] [CrossRef] [PubMed]
- Le Ouay, B.; Stellacci, F. Antibacterial activity of silver nanoparticles: A surface science insight. Nano Today 2015, 10, 339–354. [Google Scholar] [CrossRef]
- Augustine, R.; Malik, H.N.; Singhal, D.K.; Mukherjee, A.; Malakar, D.; Kalarikkal, N.; Thomas, S. Electrospun polycaprolactone/ZnO nanocomposite membranes as biomaterials with antibacterial and cell adhesion properties. J. Polym. Res. 2014, 21, 1–17. [Google Scholar] [CrossRef]
- Li, H.; Deng, Z.-Y.; Liu, R.; Loewen, S.A.; Tsao, R. Bioaccessibility, in vitro antioxidant activities and in vivo anti-inflammatory activities of a purple tomato (Solanum lycopersicum L.). Food Chem. 2014, 159, 353–360. [Google Scholar] [CrossRef]

| Treatments | Inhibition Zone (cm) |
|---|---|
| Xoo+ | |
| Bulk CS (4 µg/mL) | 0.9 ± 0.15 b |
| Bulk CS (8 µg/mL) | 1.2 ± 0.26 b |
| Bulk CS (16 µg/mL) | 1.3 ± 0.42 b |
| Xoo+ | |
| CSNPs (4 µg/mL) | 2.1 ± 0.42 a |
| CSNPs (8 µg/mL) | 2.3 ± 0.21 a |
| CSNPs (16 µg/mL) | 2.4 ± 0.26 a |
| Xoo+ | |
| Bulk ZnO (4 µg/mL) | 1.4 ± 0.16 b |
| Bulk ZnO (8 µg/mL) | 1.5 ± 0.16 b |
| Bulk ZnO (16 µg/mL) | 1.8 ± 0.16 b |
| Xoo+ | |
| ZnONPs (4 µg/mL) | 2.4 ± 0.21 a |
| ZnONPs (8 µg/mL) | 2.6 ± 0.21 a |
| ZnONPs (16 µg/mL) | 2.9 ± 0.10 a |
| Treatments | Bacterial Growth | Biofilm Formation | Motility (mm) |
|---|---|---|---|
| Xoo | 1.65 ± 0.02 a | 1.13 ± 0.03 a | 18.7 ± 0.02 a |
| Xoo + CSNPs (4 µg/mL) | 0.14 ± 0.00 b | 0.56 ± 0.05 b | 16.7 ± 0.47 b |
| Xoo + CSNPs (8 µg/mL) | 0.14 ± 0.00 b | 0.43 ± 0.02 bc | 15.0 ± 0.82 c |
| Xoo + CSNPs (16 µg/mL) | 0.14 ± 0.00 b | 0.34 ± 0.02 c | 12.7 ± 0.94 d |
| Xoo + ZnONPs (4 µg/mL) | 0.67 ± 0.02 b | 0.42 ± 0.01 b | 16.2 ± 0.47 b |
| Xoo + ZnONPs (8 µg/mL) | 0.43 ± 0.02 c | 0.34 ± 0.00 bc | 17.3 ± 0.82 c |
| Xoo + ZnONPs (16 µg/mL) | 0.22 ± 0.04 d | 0.27 ± 0.00 d | 14.5 ± 0.82 d |
Sample Availability: Samples of the compounds are available from the authors. | |
Publisher’s Note: MDPI stays neutral with regard to jurisdictional claims in published maps and institutional affiliations. |
© 2020 by the authors. Licensee MDPI, Basel, Switzerland. This article is an open access article distributed under the terms and conditions of the Creative Commons Attribution (CC BY) license (http://creativecommons.org/licenses/by/4.0/).
Share and Cite
Abdallah, Y.; Liu, M.; Ogunyemi, S.O.; Ahmed, T.; Fouad, H.; Abdelazez, A.; Yan, C.; Yang, Y.; Chen, J.; Li, B. Bioinspired Green Synthesis of Chitosan and Zinc Oxide Nanoparticles with Strong Antibacterial Activity against Rice Pathogen Xanthomonas oryzae pv. oryzae. Molecules 2020, 25, 4795. https://doi.org/10.3390/molecules25204795
Abdallah Y, Liu M, Ogunyemi SO, Ahmed T, Fouad H, Abdelazez A, Yan C, Yang Y, Chen J, Li B. Bioinspired Green Synthesis of Chitosan and Zinc Oxide Nanoparticles with Strong Antibacterial Activity against Rice Pathogen Xanthomonas oryzae pv. oryzae. Molecules. 2020; 25(20):4795. https://doi.org/10.3390/molecules25204795
Chicago/Turabian StyleAbdallah, Yasmine, Mengju Liu, Solabomi Olaitan Ogunyemi, Temoor Ahmed, Hatem Fouad, Amro Abdelazez, Chenqi Yan, Yong Yang, Jianping Chen, and Bin Li. 2020. "Bioinspired Green Synthesis of Chitosan and Zinc Oxide Nanoparticles with Strong Antibacterial Activity against Rice Pathogen Xanthomonas oryzae pv. oryzae" Molecules 25, no. 20: 4795. https://doi.org/10.3390/molecules25204795
APA StyleAbdallah, Y., Liu, M., Ogunyemi, S. O., Ahmed, T., Fouad, H., Abdelazez, A., Yan, C., Yang, Y., Chen, J., & Li, B. (2020). Bioinspired Green Synthesis of Chitosan and Zinc Oxide Nanoparticles with Strong Antibacterial Activity against Rice Pathogen Xanthomonas oryzae pv. oryzae. Molecules, 25(20), 4795. https://doi.org/10.3390/molecules25204795

